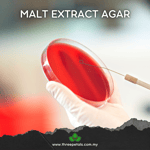
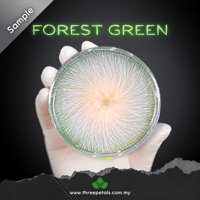
Image 6 of Sterile Pre-Poured Malt Extract Agar Plate For Mycology - Individually Sealed!

Sterile Pre-Poured Malt Extract Agar Plate For Mycology - Individually Sealed!
RM 98.00 - RM 188.00
Sold out
DETAILS:
* Malt Extract Agar (MEA)
* Food grade quality
* 90mm diameter
* Ready to use
* Individually sealed
* 100% sterile
* For clinical pharmacy, microbiology, mycology and biotechnology
IMPORTANT!
* User must be familiar with microbiology/mycology prior to use
* Item must be used within a sterile environment